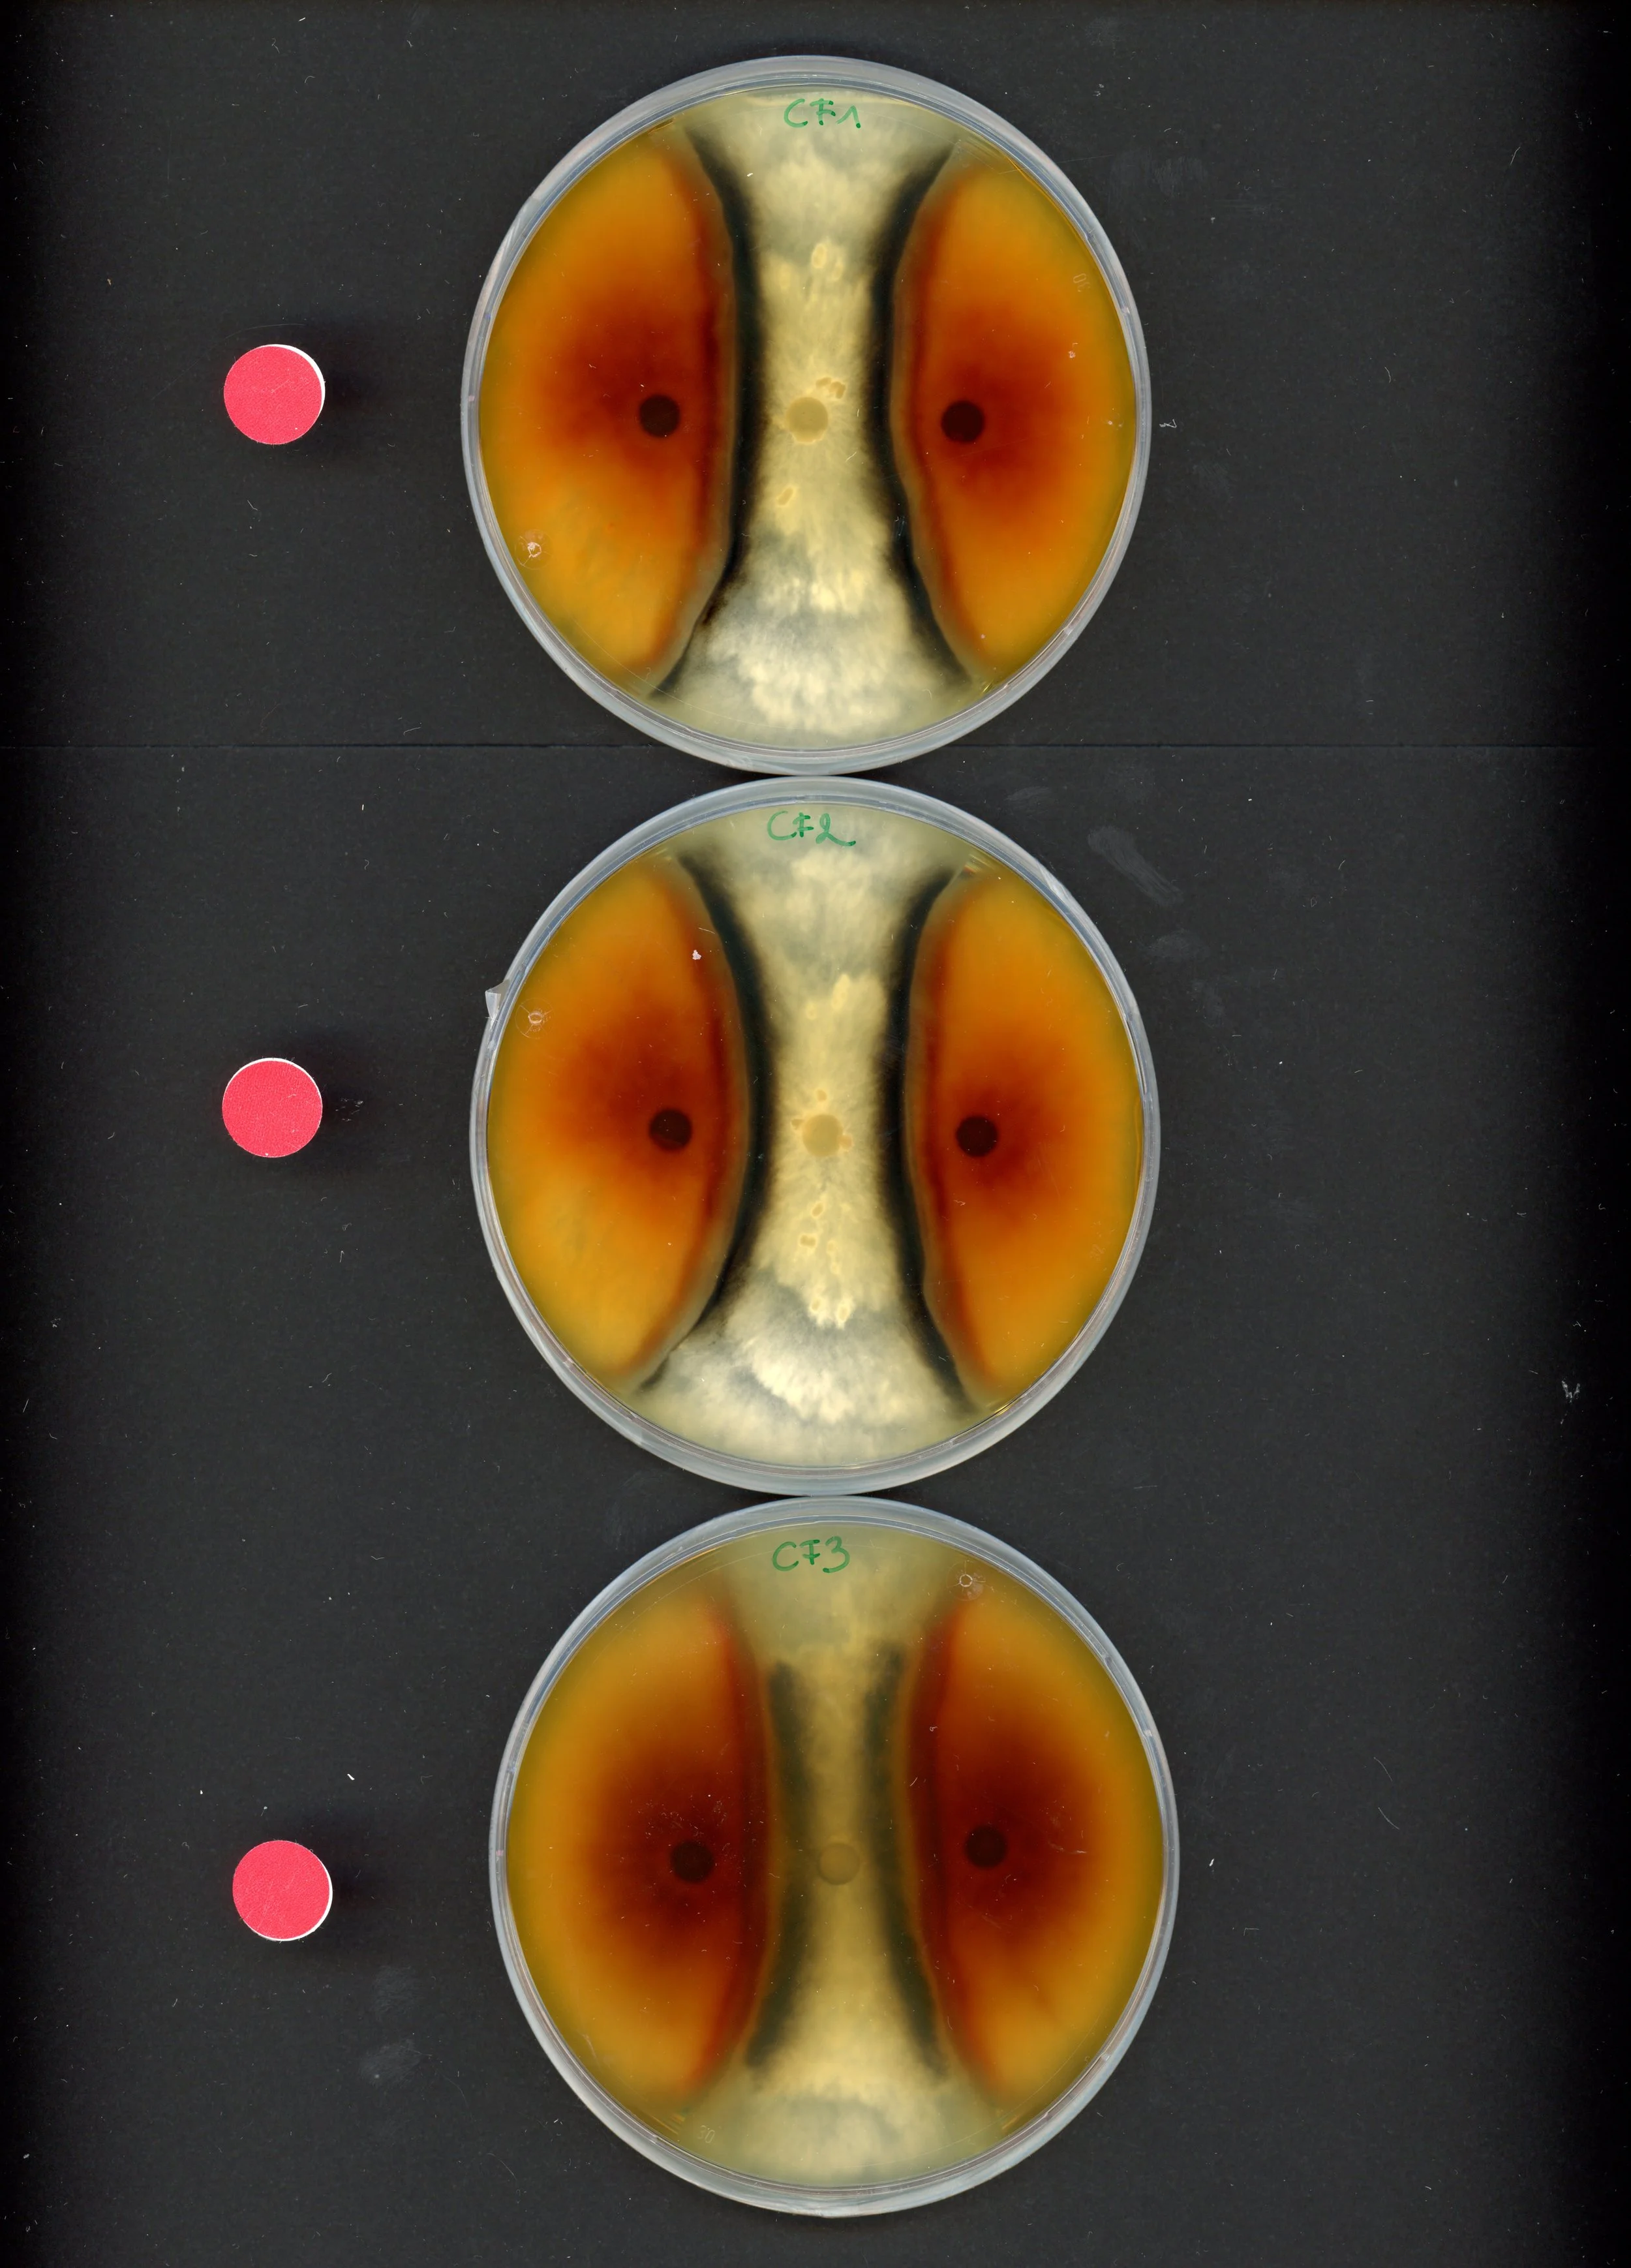
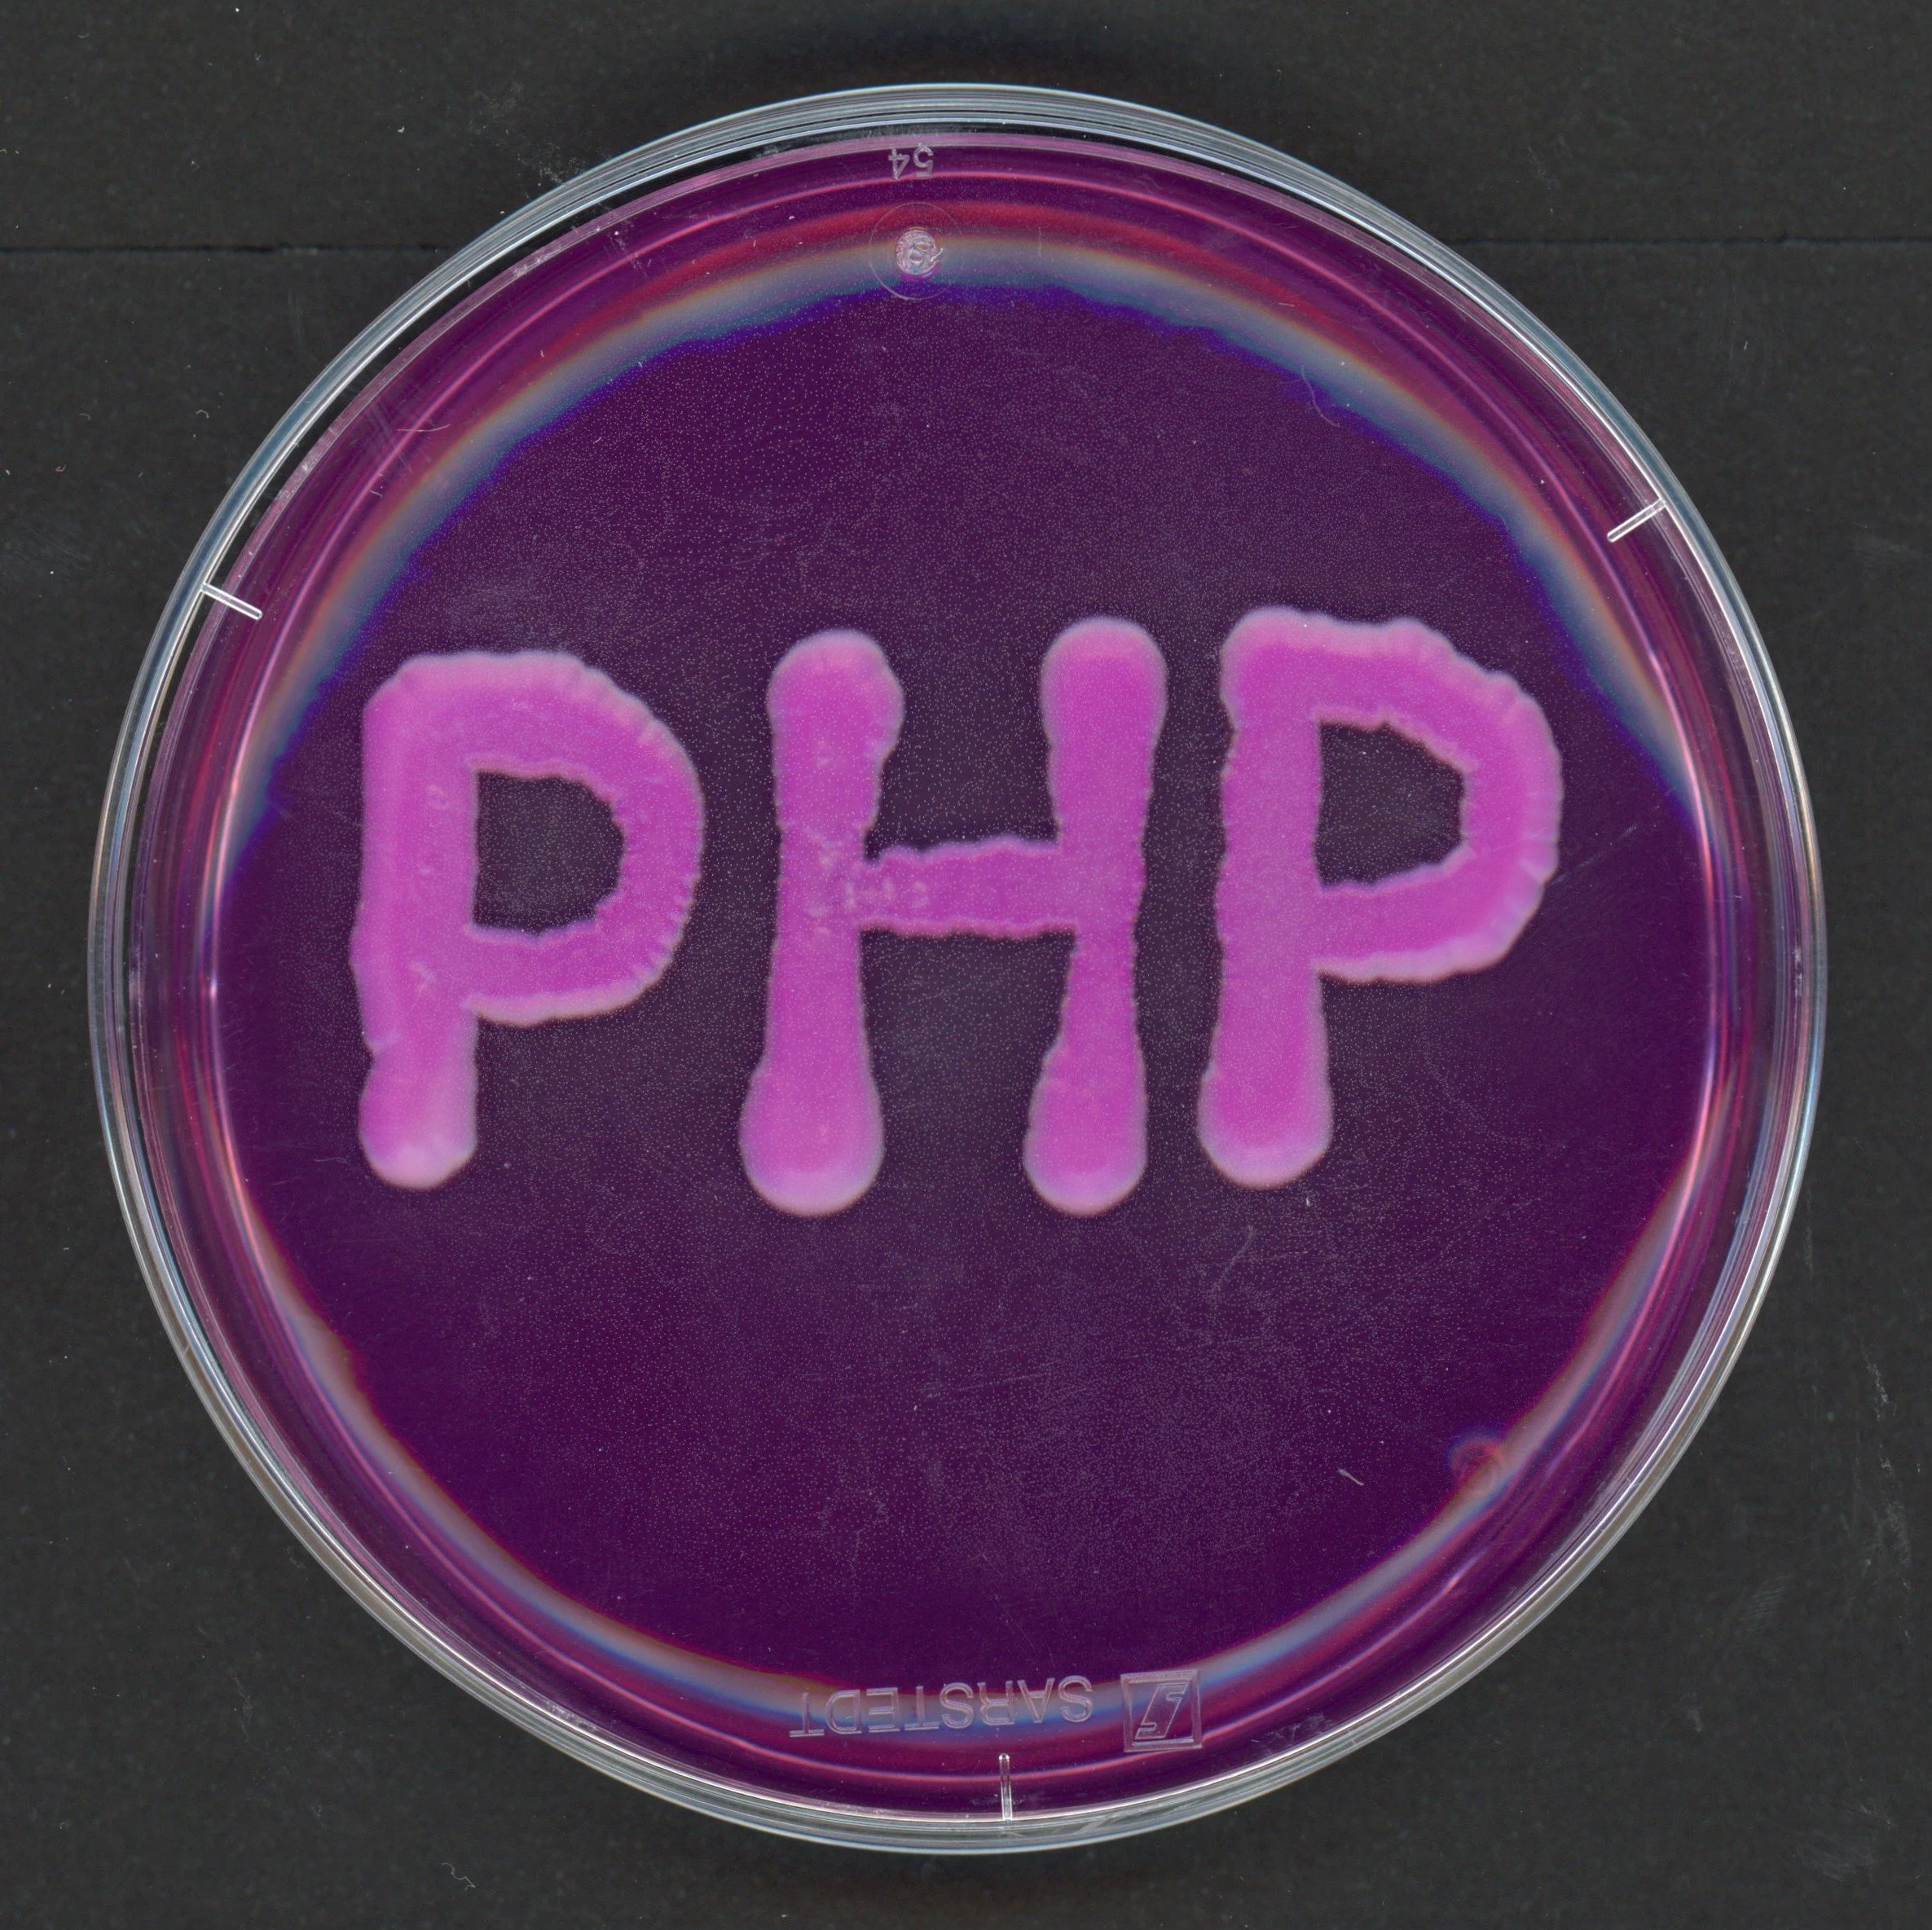
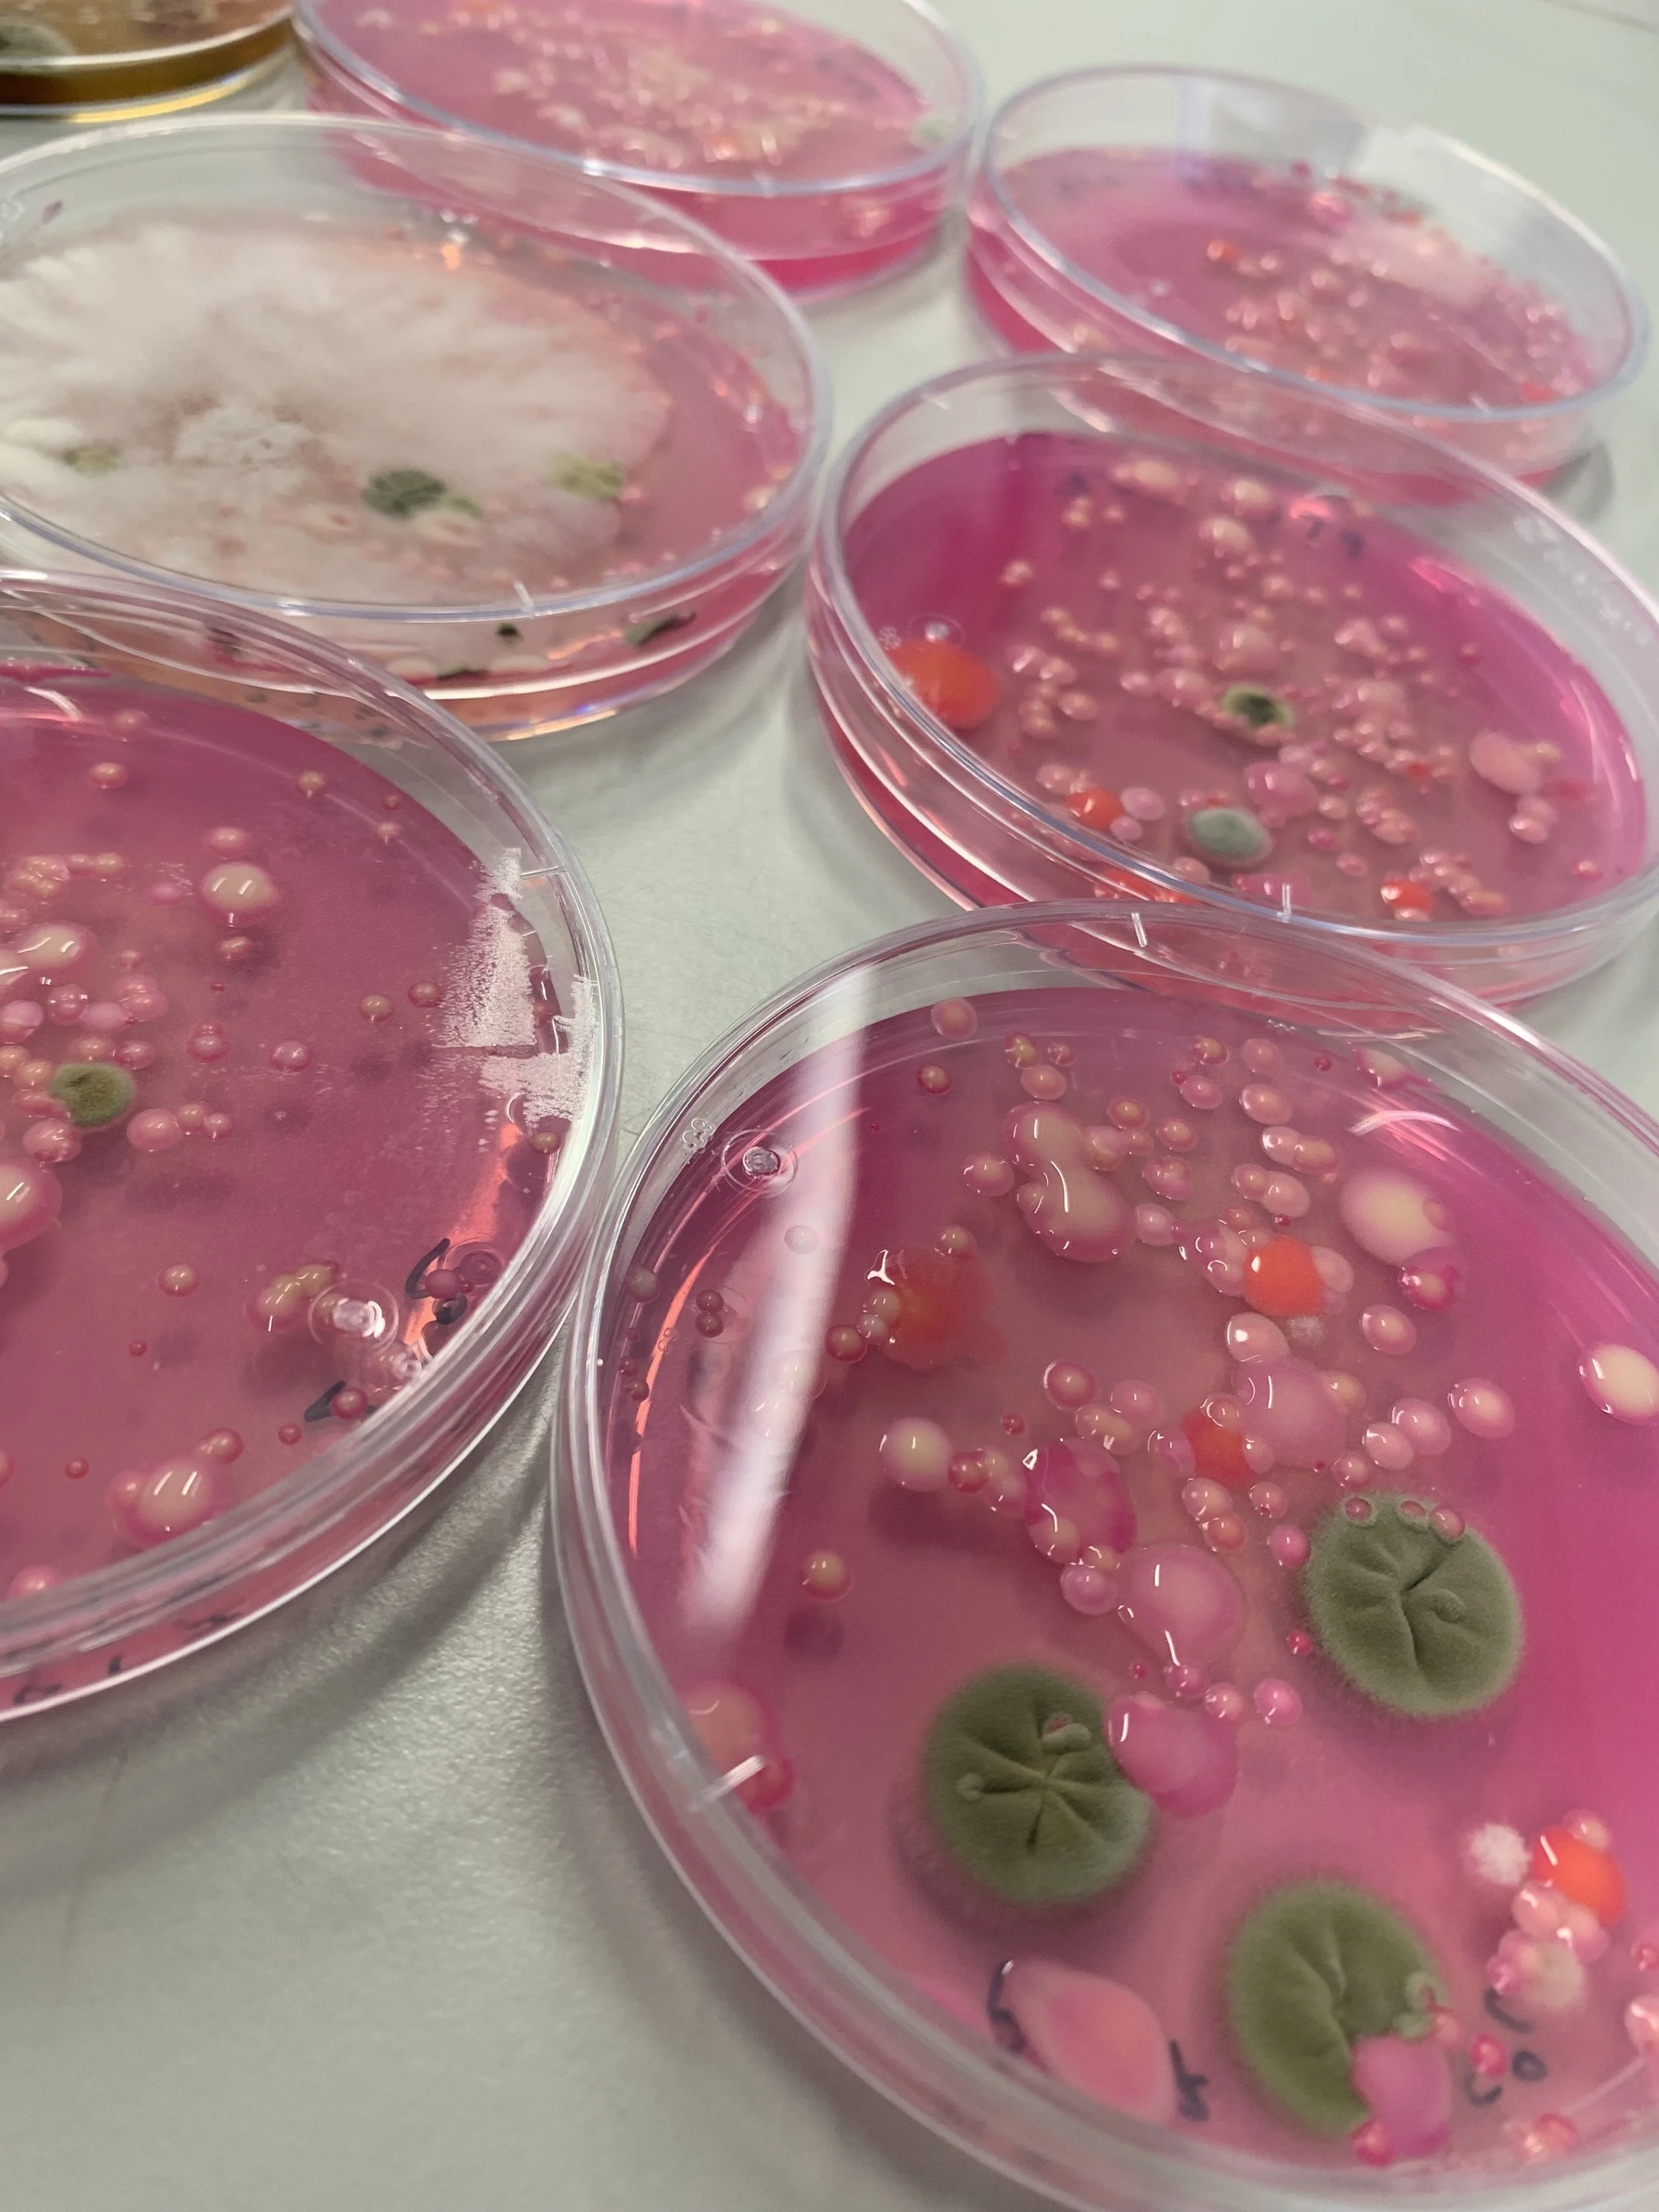

RESEARCH
Each year, plant diseases caused by diverse microorganisms such as fungi and bacteria result in substantial yield losses in economically important crops. Although chemical control was and will still be a very efficient and indispensable method of disease management in modern sustainable agriculture, chemical crop protection products face many challenges including the emergence of resistant pathogens and the adverse effects on human health and the environment. Therefore, breeders, farmers, academics, and industry are exploring innovative and alternative approaches to combat plant diseases. Potential solutions encompass the use of beneficial microorganisms, plant defense elicitors, and resistant cultivars. However, to find alternative management strategies or to select or breed for resistant cultivars further research is required to elucidate how beneficial microorganisms and plant defense elicitors are able to strengthen plant immunity or which strategies plants use to defend themselves against pathogens.
At the Plant Health and Protection Laboratory, the primary focus lies on sustainable crop protection of horticultural crops. Within the research team we specifically focus on how economically important crops such as strawberry, tomato, lettuce, pear, and banana interact with beneficial and pathogenic microorganisms and how plant immunity can be induced.
Plant defense responses
Plant yield and quality are strongly impacted by plant pathogens. To defend themselves, plants have evolved a sophisticated arsenal of defense mechanisms involving diverse biomolecules and proteins. These responses help restrict pathogen colonization, growth, and reproduction. However, through co-evolution, pathogens have developed strategies to counteract or evade plant defenses. Gaining a deeper understanding of the complex interactions between plant hosts and pathogens is essential for preventing infections and breeding more resistant cultivars.
At the PHP lab, we study the infection strategies of diverse fungal and bacterial pathogens, and aim to identify key plant proteins and metabolites that shape these distinct host–pathogen interactions.
Projects





Plant microbiome
Plants coexist with diverse microbial communities that inhabit all plant spheres, both internally (i.e., the endosphere) and externally (i.e., the ectosphere)—surrounding the roots (i.e., the rhizosphere) or aboveground organs (i.e., the phyllosphere). These microbial communities, collectively referred to as the plant microbiota, form complex interactions with plants that are crucial for their development and stress resilience. For example, the microbiota can support plant growth, enhance nutrient uptake, and suppress pathogens either directly or by priming the plant’s immune responses. This intimate association has led to the concept of the “plant holobiont”, which views the plant and its microbiome as a single functional unit. While beneficial microbes can promote plant health, pathogenic organisms may also invade these communities, disrupting microbial balance and increasing disease susceptibility. Therefore, understanding the dynamic interactions within plant-associated microbiomes is essential, particularly in the context of sustainable agriculture.
In our lab, we study the microbiomes of both above- and belowground parts of economically important crops such as strawberry, avocado, and lettuce. Our aim is to uncover how these microbial communities influence plant health and productivity, with a particular focus on developing microbiome-driven strategies to enhance crop resilience.
Projects

Induced resistance
The demand for sustainable alternatives in crop protection is more urgent than ever. Plant defense elicitors (PDEs) are promising alternatives to chemical plant protection products, which are commonly used for crop protection to prevent crop losses caused by pests and pathogens. Biobased PDEs exert their protective effect against diseases by stimulating induced resistance (IR) in plants. IR enhances the plant's defense mechanisms, leading to a faster and more robust response upon pathogen attack. However, the mode of action of PDEs and how they trigger IR are still poorly understood.
At the PHP lab, we research a variety of PDEs, including plant extracts, plant-beneficial microbes, and their specialized metabolites. Our lab has expertise in conducting various bioassays to screen PDEs and optimize their application methods. Additionally, we perform a wide range of in-depth studies to understand the modes of action of these PDEs. Our projects provide crucial insights into the plant-protecting potential of different PDEs, aiming to integrate them into the crop protection toolbox.
Projects







